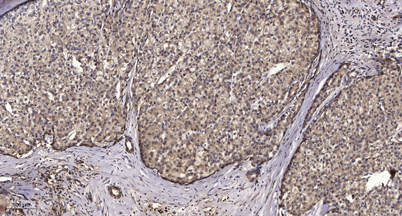

Filter options
Species-Reactivity
- a. thaliana (2)
- algae (2)
- all (207)
- aves (7)
- bovine (325)
- c. elegans (4)
- canine (221)
- deer (1)
- drosophila (5)
- duck (3)
- equine (129)
- feline (23)
- firefly (1)
- fish (13)
- gallus (214)
- goat (70)
- guinea pig (49)
- hamster (32)
- human (17362)
- insect (5)
- monkey (392)
- mouse (14027)
- other (1)
- plant (25)
- porcine (336)
- primate (61)
- protozoa (1)
- rabbit (202)
- rat (10937)
- salamander (1)
- sheep (95)
- virus (3)
- xenopus (2)
- yeast (8)
- zebrafish (71)
Manufacturer
- 2mag (80)
- 3D Bio-Tissues (13)
- 3Helix (12)
- 4basebio (27)
- A. Johnen Verpackungen (15)
- A. Rahf Laborbedarf (4)
- ABM (1)
- ABP Biosciences (760)
- ABclonal (19512)
- ADS Biotec Ltd (120)
- AHN Biotechnologie (18)
- AIT France (410)
- ALPCO (385)
- ARP American Research Products (7406)
- ATAGO (118)
- ATTO-TEC (921)
- Abbexa (344914)
- Abbkine Scientific (3418)
- Abcepta (122299)
- Abeomics (35026)
- Abiel (12)
- Abitec (5560)
- Abmole Bioscience (13198)
- Abnova (97260)
- Absolute Antibody (37308)
- Accelagen (29)
- AcroBiosystems (11731)
- Active Motif (3612)
- AddexBio (506)
- Adooq Bioscience (72532)
- Advantec (1595)
- Affinity Biosciences (33523)
- Agdia EMEA (2270)
- Agrisera (2555)
- Ahlstrom Falun (66)
- Ahlstrom-Munksjö (30)
- Alan and Co (3)
- Albert Kuhn (8)
- Almedica (6)
- Alpha Diagnostic (13915)
- Alpha Laboratories (8)
- AlphaScience (3)
- AlphaTecSystems (206)
- AlphaThera (122)
- Altmann Analytik (3)
- Amarell (168)
- Amcor (4)
- Ampersand Biosciences (130)
- Amplitech (1)
- AnaSpec (2235)
- Ananda Devices (2)
- Anatrace (1850)
- Anogen-Yes Biotech Laboratories (661)
- Antibodies Incorporated (3000)
- Antibodies.com (178725)
- Anton Paar (37)
- ApexBio (26039)
- Apollo Herkenrath (29)
- Apop Biosciences (10)
- Aptum Biologics (116)
- Arbor Assays (205)
- Arctiko (38)
- Arlington Scientific (141)
- As One (893)
- Assay Biotechnology (24651)
- Astra Biotech GmbH (56)
- Atlas Antibodies (45244)
- Aves Labs (379)
- Aviva (263068)
- Azenta (10)
- B-Safety (43)
- B. Braun (248)
- BANDELIN (314)
- BBI Solutions (636)
- BEN Biochemical (218)
- BINDER GmbH (295)
- BIO SB (4158)
- BIOMAT (381)
- BIOZOL (91)
- BMA Biomedicals (1027)
- BOCHEM Instrumente GmbH (808)
- BR Solution (36)
- BRAND (2628)
- BRinova (2)
- BT Lab (25395)
- Bachem (6294)
- Barnstead (11)
- BartelsRieger (60)
- Behr (330)
- Beijing Grinder (158)
- Bel-Art (228)
- BellBrook Labs (290)
- Benchmark Scientific (4)
- Bergmann Kartonagen (9)
- Bierbaum-Proenen (75)
- Bio X Cell (1700)
- BioActs (711)
- BioAssay Systems (477)
- BioAssay Works (103)
- BioChain Institute (2174)
- BioChem Fluidics (448)
- BioPorto Diagnostics (251)
- BioServUK (427)
- BioTeZ (205)
- BioVendor (1344)
- Biochrom (76)
- Bioconcept (456)
- Biogenex (639)
- Biolegend (35328)
- Biomatik Corporation (78744)
- Biomedica (21)
- Bionis (31)
- Biorbyt (1706984)
- Bioss (363849)
- Biosynex (118)
- Biosynth (209079)
- Biotium (47209)
- Bioworld Technology (41059)
- BlueGene (99616)
- Boettger (36)
- Bohemia Cristal (144)
- Bohlender (985)
- Boster Bio (175905)
- Brady (319)
- BrainXell (24)
- Buddeberg (60)
- BÜCHI (43)
- Bürkle (1294)
- C. Giese GmbH (52)
- CALPRO (10)
- CDN (3384)
- CETI (639)
- CH3 BioSystems (180)
- CIL (3243)
- Calibre Scientific (2)
- Cape Biologix Technologies (61)
- Caprico Biotechnologies (3584)
- Cedarlane (24834)
- Cell Biolabs (624)
- Cellcolabs (2)
- CeramTec (4)
- CertoClav (33)
- Charles River Laboratories (183)
- Chem Service (3790)
- Chondrex (906)
- Chromatrap (868)
- Citotest (6)
- Clonit (276)
- Cloud-Clone (62445)
- Cole-Parmer (189)
- Columbia Biosciences (292)
- Concise Separations (171)
- Coolike (5)
- Cope (1)
- Corning (288)
- Cortez Diagnostics (7)
- Covalab (10816)
- Creative BioMart (48868)
- Creative Biolabs (46896)
- Cryonos (87)
- Crystal (39)
- Cusabio (105948)
- Cyagen Biosciences Inc. (911)
- Cygnus Technologies (567)
- Cytognos (68)
- Cytoskeleton (438)
- DACOS (10)
- DB-Biotech (483)
- DCS Diagnostics (922)
- DIA.PRO (119)
- DIAsource ImmunoAssays (480)
- DLAB (3)
- DLDEVELOP (30458)
- DOSTMANN electronic (109)
- DRG Instruments (585)
- DWK Life Sciences (1879)
- DYMO (117)
- Daresbury Proteins (58)
- Deutsch und Neumann (447)
- Dextra Laboratories (656)
- Diba (1341)
- Dietmar Knabe (2)
- Dojindo (464)
- Dominique Dutscher (4)
- Dr. Ehrenstorfer (9208)
- Dr. Weigert (54)
- Dräger (147)
- DuPont (28)
- ELITech (31)
- ELK Biotechnology (25552)
- ESCO Lifesciences GmbH (211)
- EXBIO (4772)
- EXCELITAS (20)
- EastCoast Bio (2077)
- Ebba Biotech (189)
- Echelon Biosciences (2197)
- Ecoli Dx, s.r.o. (270)
- EdgeBio (181)
- Elabscience (32030)
- Elkay (25)
- Elma Schmidbauer GmbH (129)
- Encapsula NanoSciences (17)
- Endotherm (785)
- EnkiLife (29464)
- Enzo Life Sciences (6664)
- Epredia (233)
- EuroClone (431)
- Eurocell (13)
- Everest (6868)
- Excelitas Noblelight GmbH (313)
- FRYKA (24)
- FabGennix (6741)
- Fahsig (3)
- Firebird Optics (52)
- Firefly (915)
- Fluorochem (137351)
- Focus Biomolecules (1697)
- Franz Mensch (19)
- Fritsch (296)
- Fritz Arndt (10)
- Fuller (175)
- Fuller Laboratories (10)
- Funke Gerber (110)
- Future Fields (7)
- GA INTERNATIONAL (41)
- GVS (49)
- Ganterie (4)
- Gebra (40)
- GeneDireX (241)
- GeneTex (48410)
- Generic Assays / Medipan (4)
- Genesee Scientific (5549)
- GenomeMe (535)
- Genscript (14272)
- Gentian (8)
- GenuIN Biotechnologies (8157)
- Gerber Instruments (120)
- Gerd Schneider (12)
- Gerhard Analytical Systems (2)
- Glindemann (8)
- Golden Gate Scientific (4)
- Gorr Transporttechnik (26)
- Grant (378)
- Grauer (14)
- Green Mountain Antibodies (110)
- Greiner Bio-One (74)
- Grün-Pumpen (10)
- Guangzhou JET Bio-Filtration (210)
- HCL (23)
- HK-Pack (23)
- HORO Dr. Hofmann (4)
- HUABIO (10991)
- HUMAN (222)
- HWS Labortechnik (71)
- Hahnemühle (327)
- Hailo (5)
- Hanhart Chronographen 1882 (15)
- HansaBioMed (174)
- Hardy Diagnostics (3093)
- Harry Gestigkeit (71)
- Hartmann (37)
- Heathrow Scientific (502)
- Hecht Glaswarenfabrik (236)
- Heidolph (64)
- Heinz Herenz Hamburg (55)
- Hellma (185)
- HelloBio (1480)
- Heraeus Noblelight (71)
- Hettich Benelux (93)
- Hielscher Ultrasonics (30)
- High Purity Standards (1780)
- Hilgenberg (50)
- Hirschmann Laborgeräte (844)
- Honeywell Safety Products (54)
- Hospidex (22)
- Huber (245)
- Huixia (13)
- Hycult (1366)
- Hülden (17)
- Hünersdorff (99)
- IBA (200)
- IBI Scientific (1603)
- ICL (1360)
- IDCP B.V. (55)
- IHC WORLD (635)
- IKA (1196)
- ION Biosciences (119)
- IPHASE Biosciences (931)
- IQ Products (472)
- ISOHEAT GmbH (155)
- ISOLAB (703)
- Ideal-tek (66)
- Igefa (22)
- ImmuQuest (515)
- ImmunoChemistry Technologies (503)
- ImmunoReagents (1114)
- Immunostep (483)
- Industrial Physics (44)
- Ingenetix (497)
- Interstuhl (95)
- Invent BioTechnologies (80)
- Isca Biochemicals (444)
- JUTEC (23)
- Jackson ImmunoResearch (3942)
- Johann W. Schimmel (11)
- Juchheim Laborgeräte (54)
- Julabo (355)
- KD Scientific (18)
- KGW-Isotherm (195)
- KINEMATICA GmbH (114)
- Kaiser (2)
- Kamiya Biomedical Company (2277)
- Karl Hammacher (124)
- Kartell LABWARE (605)
- Kautex (295)
- Kementec (81)
- Kerafast (4150)
- Kern und Sohn (1465)
- Keter Luxembourg (1)
- Key Surgical (5)
- Kimberly-Clark (81)
- Kleinfeld Labortechnik (13)
- Klett Kunststofftechnik (12)
- Konus Italia Group (22)
- Korff (36)
- Krishgen Biosystems (28881)
- Kroschke (26)
- Krüss (49)
- Kundert Vario (10)
- Köttermann (56)
- LAUDA (127)
- LEHRICH (19)
- LEONHARDY VP (29)
- LGC Standards (60)
- LKT Labs (3156)
- LLG Labware (15028)
- LMS Consult (1)
- LOSCH (1)
- La-Pha-Pack (80)
- Lab-Club (4190)
- Laborgeräte Süd (18)
- Lampire Biological Labs (2118)
- Lamy Rheology (91)
- Langkavel Office + Lab (24)
- Larodan (478)
- Leadgene Biomedical (1023)
- Lenz Laborglas (1422)
- Licefa (1)
- Liebherr (93)
- LifeSpan Biosciences (1295453)
- LifeTein (24)
- Liga Trap Technologies (37)
- Linaris (5847)
- Linker Industrie-Technik (278)
- Liposoma research (100)
- List Biological Labs (81)
- Ludwig Schneider (384)
- Lutz Pumpen (35)
- Lybe Scientific (19)
- MABTECH (1656)
- MAPA (141)
- MBL (4794)
- MEDITE (3)
- MERCK Millipore (21)
- MP Biomedicals Germany (6645)
- MS Validated Antibodies (543)
- Maassen GmbH (17)
- Macherey-Nagel (2085)
- Manulatex (21)
- Marienfeld (158)
- Matriks Biotechnology (101)
- MaxVision Biosciences (112)
- MedNet (12)
- MedSchenker (14)
- MedchemExpress (210098)
- Medix Biochemica (1574)
- Memmert (286)
- Merck (68)
- MetallWarenfabrik Mühlacker (10)
- Mettler-Toledo (610)
- Micros Produktion (17)
- Miele (87)
- Mikromol (6967)
- Millipore (223)
- Mirus Bio (166)
- MoBiTec (318)
- Molecular Dimension (2136)
- Monosan (2458)
- Montana Molecular (189)
- Morgan Advanced Materials (217)
- MyBiosource (2436584)
- NABAS (24)
- NORMA (75)
- NSJ Bioreagents (37697)
- NZYtech (3479)
- Nabertherm (219)
- NanoHelix (186)
- NanoTag Biotechnologies (282)
- Nanoprobes (231)
- Nasco Sampling (49)
- NeXtal (381)
- NeoBiotechnologies (17253)
- Neuromics (2384)
- Nexotech (6)
- Nitritex (131)
- Nordic BioSite (473908)
- Nordic Lab (60)
- NordicMubio (2858)
- Normag (4)
- Normax (4)
- Normensand (1)
- Novelis Deutschland GmbH (16)
- OHAUS (915)
- OLM Diagnostics (3)
- OMNILAB (10)
- ORI (3)
- OSRAM (142)
- OZ Biosciences (693)
- OaCP (114)
- Oasis Diagnostics (14)
- Obermeier (7)
- Operon (98)
- Oxford Biomedical Research (955)
- P/S Kunststoffwerke (18)
- PBL Assay Science (138)
- PGP (35)
- PMS TIP TEKNOLOJILERI (45)
- PanPath (692)
- Peak Scientific (7)
- Pfennig Reinigungstechnik GmbH (40)
- Phoenix Instrument (37)
- Phosphosolutions (7)
- Poly-Dtech (76)
- PolyScience (87)
- PrimerDesign (2588)
- ProFoldin (497)
- ProSci (46610)
- ProSpec-Tany Technogene (7023)
- ProteinArk (1162)
- ProteoGenix (31040)
- Qkine (611)
- Quantimetrix (39)
- RD-Biotech (42)
- RJH Biosciences (30)
- ROBU (134)
- ROMMELSBACHER (3)
- RSG Rostfrei (84)
- Randox (2)
- Ratiolab (280)
- Rauschenberger Innovations (4)
- RayBiotech (113105)
- Reagecon (3493)
- Reagena (34)
- Reed Biotech (10548)
- Reitenspieß-Bürsten (97)
- Reliance Biosciences (3)
- Reprocell (268)
- Resch Laborglas (32)
- Retsch (930)
- Rettberg (37)
- RevMAb (461)
- Riken Keiki (30)
- Rische + Herfurth (46)
- Ritter (99)
- Roboscreen (181)
- Rockland Immunochemicals (12667)
- Roland Watzdorf (18)
- Rometsch GmbH (15)
- Rötzmeier Sicherheitsbehälter (76)
- S-Bio (240)
- SCAT Europe GmbH (390)
- SHP (50)
- SOCOREX (366)
- Saint-Gobain (586)
- Salimetrics (57)
- Sanyou Bio (1567)
- Saropack (1)
- Sarstedt (6)
- Sartorius (1819)
- Sceti (3913)
- Scherf Präzision (164)
- Schorpp (9)
- Schott (66)
- Schwan (35)
- Schwegmann Filtrations (31)
- Schweizer (5)
- Schülke und Mayr (13)
- Scientific Industries (83)
- ScyTek Laboratories (2879)
- SeLENOZYME (91)
- Selleck (24035)
- Semperit (67)
- Seramun Diagnostica (33)
- SiLI (17)
- Sievert (2)
- SignalChem (2274)
- SignalChem Diagnostics (776)
- Sileks (16)
- Silnova (20)
- Sino Biological (240903)
- Snoltherm (63)
- Somagenics (164)
- Sonation (4)
- Sonepar Deutschland (4)
- Sontara (9)
- SouthernBiotech (3537)
- Spherotech (1017)
- Starke Laborbedarf (32)
- Starna (25)
- Statens Serum Institut (321)
- StemBioSys (94)
- Sterilin (38)
- Surplus Systems (16)
- Svanova (38)
- Svar Life Science (67)
- Synabs (1241)
- SÖHNGEN (53)
- TENAK (662)
- TFA Dostmann (82)
- TNC Bio (8)
- TOKU-E (2837)
- TargetMol (159536)
- TdB Labs (286)
- The Native Antigen Company (1628)
- Thermax (14)
- Thermo Elect.LED GmbH (1060)
- Thies Clima (2)
- Thomas Pumpen (45)
- Tintometer (458)
- Toronto Bioscience (361)
- Toronto Research Chemicals (94059)
- Trevigen (338)
- Trinity Biotech (51)
- U-CyTech biosciences (341)
- UBPBio, LLC (810)
- UCS Diagnostics (1)
- US Biological (538744)
- USBECK (240)
- Umweltanalytik Holbach (12)
- Unigloves (271)
- Ushio (36)
- VIDIA (114)
- VITRO (2246)
- VMRD (275)
- VOLTRONIC (35)
- VWR (26)
- Vacuubrand (417)
- Vazyme Biotech (991)
- Vector Biolabs (536)
- Vector Laboratories (2564)
- VectorBuilder (537)
- Velp Scientifica (189)
- Vikan (90)
- Virax Biolabs (94)
- ViroStat (1323)
- Virusys (160)
- VmP (8)
- WEDO (38)
- Waldmann (2)
- Waring (17)
- Water-i.d. (105)
- Werner Arzneimittel (1)
- Wilhelm Schröder (9)
- Wolf Maschinenbau AG (4)
- Württ. Drahtwarenfabrik (66)
- Württembergische Allplastik (14)
- Xylem Analytics (660)
- Yashraj Biotechnology (55)
- YouSeq (681)
- ZIRBUS technology (62)
- ZVG Zellstoffvertrieb (38)
- ZellBio (154)
- Zytomed Systems (7764)
- asecos (100)
- baseclick (242)
- biomedis (2)
- dianova (1635)
- edding (140)
- eutecma (18)
- eversyn (8)
- helo (4)
- highQu (125)
- interscience (88)
- magtivio (227)
- messner emtronic (21)
- nanoComposix (538)
- nanoimmunotech (214)
- peptides and elephants (1871)
- proQuarz (49)
- reddot Biotech (34636)
- schuett-biotec (234)
- stakpure (79)
- tec-lab (17)
- tesa (5)
- trenzyme (194)
- uvex (370)
SPTN2 rabbit pAb, Rabbit, Polyclonal
- Images: 2
- Applications: 2
| Biozol Catalog Number: | EBT-ES12970 |
| Manufacturer: | ELK Biotechnology |
| Application: | IHC, WB |
| Category: | Antikörper |
| Size: | 50 µL, 100 µL |
| Show Prices | |


(2) Images
SPT22 rabbit pAb, Rabbit, Polyclonal
- Images: 2
- Applications: 2
| Biozol Catalog Number: | EBT-ES12975 |
| Manufacturer: | ELK Biotechnology |
| Application: | IHC, WB |
| Category: | Antikörper |
| Size: | 50 µL, 100 µL |
| Show Prices | |

(2) Images
SPT20 rabbit pAb, Rabbit, Polyclonal
- Images: 2
- Applications: 2
| Biozol Catalog Number: | EBT-ES12976 |
| Manufacturer: | ELK Biotechnology |
| Application: | IHC, WB |
| Category: | Antikörper |
| Size: | 50 µL, 100 µL |
| Show Prices | |


(2) Images
SPSY rabbit pAb, Rabbit, Polyclonal
- Images: 2
- Applications: 3
| Biozol Catalog Number: | EBT-ES12978 |
| Manufacturer: | ELK Biotechnology |
| Application: | ELISA, IHC, WB |
| Category: | Antikörper |
| Size: | 50 µL, 100 µL |
| Show Prices | |


(2) Images
SPRE2 rabbit pAb, Rabbit, Polyclonal
- Images: 2
- Applications: 2
| Biozol Catalog Number: | EBT-ES12983 |
| Manufacturer: | ELK Biotechnology |
| Application: | IHC, WB |
| Category: | Antikörper |
| Size: | 50 µL, 100 µL |
| Show Prices | |


(2) Images
SPP2A rabbit pAb, Rabbit, Polyclonal
- Images: 2
- Applications: 2
| Biozol Catalog Number: | EBT-ES12985 |
| Manufacturer: | ELK Biotechnology |
| Application: | IHC, WB |
| Category: | Antikörper |
| Size: | 50 µL, 100 µL |
| Show Prices | |


(2) Images
SPI2B rabbit pAb, Rabbit, Polyclonal
- Images: 2
- Applications: 3
| Biozol Catalog Number: | EBT-ES12990 |
| Manufacturer: | ELK Biotechnology |
| Application: | ELISA, IHC, WB |
| Category: | Antikörper |
| Size: | 50 µL, 100 µL |
| Show Prices | |


(2) Images
SPG16 rabbit pAb, Rabbit, Polyclonal
- Images: 2
- Applications: 3
| Biozol Catalog Number: | EBT-ES12992 |
| Manufacturer: | ELK Biotechnology |
| Application: | ELISA, IHC, WB |
| Category: | Antikörper |
| Size: | 50 µL, 100 µL |
| Show Prices | |


(2) Images
SPAT2 rabbit pAb, Rabbit, Polyclonal
- Images: 2
- Applications: 3
| Biozol Catalog Number: | EBT-ES12998 |
| Manufacturer: | ELK Biotechnology |
| Application: | ELISA, IHC, WB |
| Category: | Antikörper |
| Size: | 50 µL, 100 µL |
| Show Prices | |


(2) Images
SPAC7 rabbit pAb, Rabbit, Polyclonal
- Images: 2
- Applications: 3
| Biozol Catalog Number: | EBT-ES13000 |
| Manufacturer: | ELK Biotechnology |
| Application: | ELISA, IHC, WB |
| Category: | Antikörper |
| Size: | 50 µL, 100 µL |
| Show Prices | |


(2) Images

